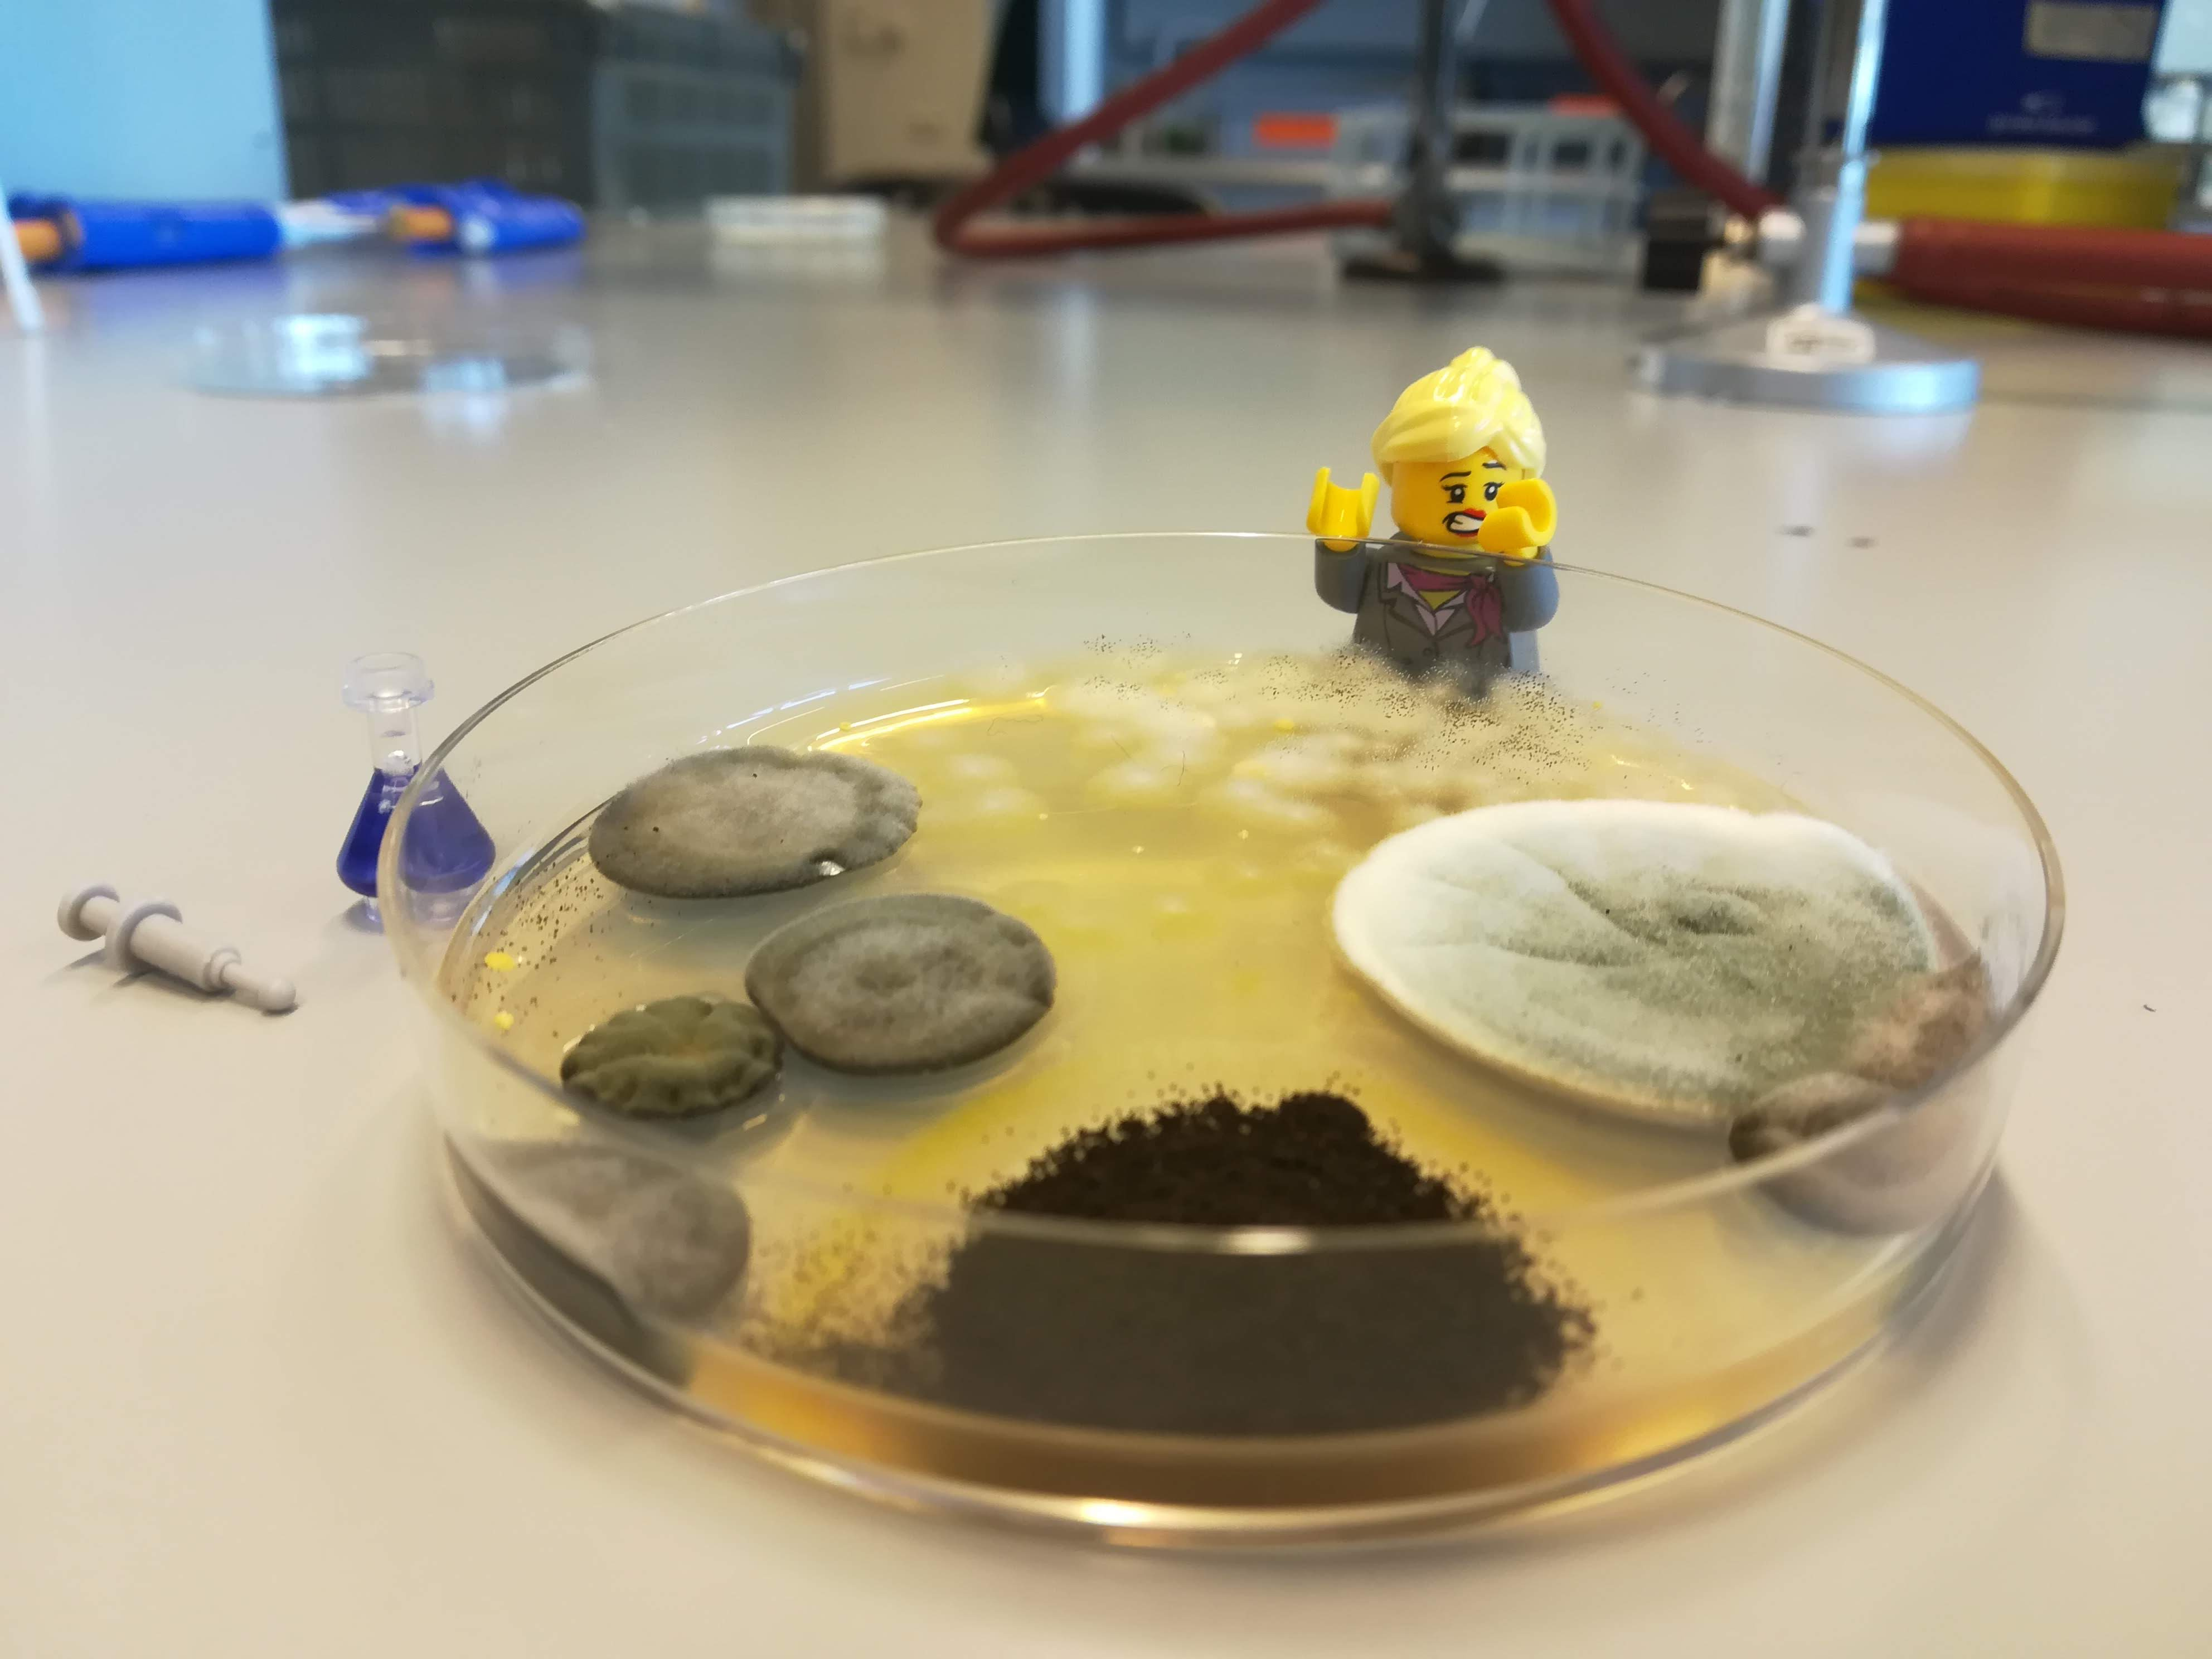

Building a paper with Lego®
Published in Microbiology, Protocols & Methods, and Anatomy & Physiology

The first brick
The story behind this paper already started during my Master studies in 2016, when I had to give a presentation on O-glycosylation. My fellow students and I decided to use Lego® to explain how O-glycans are built, not surprising given the color palette of the symbols used in glycobiology (Picture 1). However, the presentation did not have the impact we had hoped for. The teacher of the course, my mentor, decided to gift me a Lego® minifigure of a female scientist when I graduated, with a nod to the failed presentation. Never had I expected that my academic adventure, that was just about to start, would actually take me to the country where Lego® was invented…

Starting a PhD
After my MSc graduation in 2017, I started a PhD in the Laboratory of Microbiology in Wageningen. In this lab, I had just completed my Master thesis on the degradation of human milk oligosaccharides by the mucin-degrading specialist Akkermansia muciniphila. As I was also interested in the host side, however, my PhD project was taking a slightly different direction and I was going to work on an in vitro model (gut-on-a-chip) to study host-microbe interactions in the human gastrointestinal tract. Like A. muciniphila, I had fallen in love with mucins, so I put my focus on recreating a mucus layer in vitro. Mucins are fascinatingly complex molecules, as the protein backbone is basically coded with lots of proline, threonine and serine (the so-called PTS-domains), decorated with O-glycans. Note that at the time we did not focus on mucin O-glycosylation yet, but rather on the presence of MUC2 (the main type found in colonic mucus) and a thicker mucus layer, as opposed to conventional in vitro models.
#PhDlife
As my PhD project progressed, the Lego® minifigure of the female scientist had become my mascot. A colleague and I made her an Instagram account and posted puns about PhD life (Picture 2). While we were making fun of PhD life not always going as planned, the “building instructions” of the gut-on-chip were also more difficult to follow than anticipated. But just as with Lego®, using similar or other bricks you can still build more or less the same construction (in this case, a PhD thesis). Therefore, the focus of my PhD project shifted more towards the relatively underexplored interactions of A. muciniphila and mucus O-glycosylation in vitro. This is the point at which colleague Hanne Tytgat, who was not involved in the gut-on-chip project, decided to jump in. She had established a collaboration with Henrik Clausen and Yoshiki Narimatsu from the Copenhagen Centre for Glycomics (CCG), a glycobiology lab at the University of Copenhagen. Together they explored the binding of A. muciniphila to mucin using mucin reporters previously developed by CCG. These reporters represent pieces of mucin molecules, in which the protein backbone and O-glycan composition can be designed as desired. Potentially, these reporters could help elucidate the binding properties of A. muciniphila, and thus, this side project could fit within the scope of my PhD.
Picture 2: Example of content posted on Instagram. Caption used: “Monday… as usual, I’ve got too much on my plate. #phdproblems #laboratorylife.”
From the first experiments…
The establishment and optimization of the ELISA to study the binding of A. muciniphila to mucin, which forms the basis of the paper, went relatively smoothly. I remember that during the lockdown, we were only allowed to work six consecutive hours per day in the lab, in which we could exactly fit the ELISA protocol. This made the lab days pretty efficient. The initial experiments in 2020 showed some interesting results that we decided to further investigate. We could expand the ELISA to different mucin types (MUC1, 2, 5AC, etc.) and O-glycoforms. The results became more and more clear: the binding of A. muciniphila to mucin is dependent on O-glycans (the Lego® bricks!), especially the ones that form the Core2 and 3 structures.
… to the final stretch
When the covid pandemic seemed to reach its end, I had about one year left to wrap up my PhD. Although the chapter on the binding of A. muciniphila was considered a side project, I really wanted to finish it properly, as it showed promising results. So far, we had been collaborating with our colleagues in Copenhagen at a distance: they shipped the reporters to the Netherlands, where we cultivated A. muciniphila to investigate the binding. At this point, however, our collaborators thought it would be nice if I would come to Copenhagen, to see how the mucin reporters are produced, to perform some additional experiments and to expand my glycobiology skills. We wrote a travel grant, allowing me to do experiments for three months abroad, which would fit exactly within my PhD time plan. The grant got awarded and moreover, this meant that my Lego® mascot would return home!
Off to Legoland®!
Besides the grant, I was only one obstacle away from going abroad: we could not grow A. muciniphila (anaerobically) in a glycobiology lab, neither could we perform subsequent binding experiments with live bacteria. This was one of the reasons we wanted to see if the binding properties we had observed were also true for pasteurized A. muciniphila. This turned out to be the case and A. muciniphila, my mascot and I were ready to go. Sadly, while preparing for my journey, Instagram deleted the account due to an administrational error. Although I was not able to post about my mascot’s adventures in Denmark, once in Copenhagen, I actually learnt how Lego® truly is built: I learnt more about glycobiology than I have could done at home. Moreover, we also managed to further explore the binding of A. muciniphila by flow cytometry. These experiments confirmed that LacNAc, abundantly present in the human colon (mainly MUC2 Core3), is the favorite binding epitope of A. muciniphila.

The finishing touch
After leaving Copenhagen again, I finished my final experiments at home and wrote my PhD thesis. During this period, I explored the opportunities for a Postdoc and decided that I wanted to stay at the interface of glycobiology and microbiology. Luckily, CCG had a position available, so after defending my PhD thesis (Lego®-themed, Picture 3) I started my Postdoc in Copenhagen to continue in the field. This also allowed us to finish and polish the publication on A. muciniphila and carry out some additional experiments to improve the work, resulting in the current publication.
Did I get tired of building Lego® in the meantime? Of course not! During a science outreach event at the University of Copenhagen last year, we used Lego® to explain the concept of mucin O-glycans (Picture 4) and this time, the presentation was a success.

Follow the Topic
-
Nature Communications
An open access, multidisciplinary journal dedicated to publishing high-quality research in all areas of the biological, health, physical, chemical and Earth sciences.
Related Collections
With Collections, you can get published faster and increase your visibility.
Women's Health
Publishing Model: Hybrid
Deadline: Ongoing
Biosensing
Publishing Model: Hybrid
Deadline: Sep 30, 2026





Please sign in or register for FREE
If you are a registered user on Research Communities by Springer Nature, please sign in